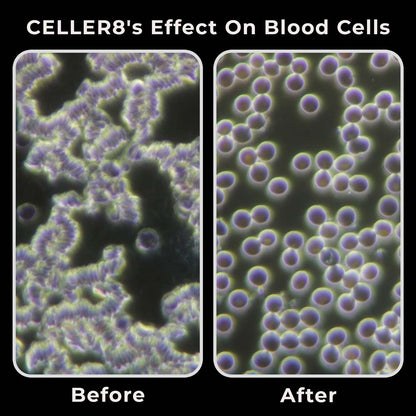
CELLER8® Small Pet Package - Arumi Companions

Celler8
CELLER8® Full Body Mat Package
CELLER8® Full Body Mat Package
Couldn't load pickup availability
Share













- Description
- Key Features:
- Specifications:
- Warranty
- Delivery & Returns
CELLER8® Full Body Mat Package
Experience the ultimate in PEMF therapy with our premium full body mat. This comprehensive package includes everything you need for professional-grade wellness treatments at home.
The ultimate all-in-one PEMF therapy package, including both full-body and localized application.
-
2 In 1 Package - Full Body + Localised
-
Easy To Use - Preset + Custom Programs
-
Portable - Use Anywhere Anytime
-
Rechargeable Battery - Up to 44 Hours
-
Create The Optimal Environment to Heal
- Professional-grade PEMF technology
- Multiple intensity levels
- Pre-programmed wellness protocols
- Portable and easy to use
- Suitable for whole-body treatment
Benefits:
- Supports natural recovery processes
- Promotes relaxation and wellbeing
- Convenient home therapy solution
- Trusted by wellness professionals
-
Specifications
CELLER8:
Intensity:1 – 100 Gauss (100 - 10,000 µT)
Frequency:1 – 100 Hz
Application: Localised
Number of programs: 5
Program length:5 mins – 12 hours
Number of coils: 1
Polarity:North, South & Alternating
Waveform: CELLER8 unique square wave
Slew Rate: <68T/s
Size: 14cm x 14cm x 3.2cm
Weight:
250 grams
Full Body Mat:
Intensity:1 – 50 Gauss Per Coil (1 - 5,000 µT)
Frequency:1 – 100 Hz
Application: Full body
Number of programs: 5
Program length:5 mins – 12 hours
Number of coils: 12
Polarity:North, South & Alternating
Waveform: CELLER8 unique square wave
Slew Rate:<68T/s
Mat Size:169cm x 49cm x 2.2cm
Mat Size Folded:42cm x 49cm x 10cm
Weight:3500 grams
Certifications: CELLER8 is a general wellness device certified to CE, UKCA & manufactured in an FDA-registered facility (Establishment Number: 3002806497)
At CELLER8, we believe in the quality and longevity of our products. That's why we offer extended warranties to provide you with added peace of mind. The CELLER8 comes with an impressive 3-year warranty, while our full-body mat is covered by a 2-year warranty.
Delivery & Returns Policy
At Arumi Companions, we are committed to delivering your order safely, efficiently, and with care. Please review our delivery and returns policy below for details on processing times, delivery methods, and return expectations.
Order Processing
-
Orders are typically processed within 1–3 business days (excluding weekends and holidays).
-
Once your order has been processed and shipped, you will receive a shipping confirmation email with tracking information.
-
Processing times may be extended during high-demand periods, promotions, or holidays.
Shipping Methods & Delivery Times
We offer reliable shipping services through trusted carriers.
Estimated delivery times:
-
Standard Shipping: 3–7 business days after shipment
-
Expedited Shipping: 2–3 business days after shipment (if available at checkout)
Delivery times are estimates and may vary due to carrier delays, weather conditions, or other factors beyond our control within the UK.
Shipping Rates
-
Shipping costs are calculated at checkout based on order size, weight, and destination.
-
Any applicable shipping promotions or free shipping offers will be clearly displayed at checkout.
Shipping Locations
United Kingdom Only
-
We currently ship within the United Kingdom only.
-
At this time, we do not offer international shipping.
Order Tracking
Once your order ships, tracking details will be provided via email. Please allow up to 24 hours for tracking information to update.
Shipping Address Accuracy
Please ensure all shipping information is accurate at checkout. Arumi Companions is not responsible for delays, lost packages, or additional fees resulting from incorrect or incomplete address details.
Lost or Delayed Packages
If your package is delayed or appears lost in transit, please contact us at contact@arumicompanions.co.uk. and we will assist you in working with the carrier.
Damaged Shipments
If your order arrives damaged, please notify us within 48 hours of delivery. Include photos of the damaged packaging and product so we can promptly assist with a resolution.
Returns & Refunds
-
If you wish to return an item, please contact us within 14 days of delivery.
-
Items must be unused, in original condition, and returned in original packaging.
-
Due to the nature of wellness and therapy products, certain items may be exempt from return for hygiene or safety reasons unless faulty.
-
Return shipping costs are the responsibility of the customer unless the item is faulty or incorrect.
Refunds will be issued to the original payment method once the returned item has been received and inspected.
Questions
If you have any questions regarding delivery or returns, please contact our customer support team at contact@arumicompanions.co.uk.
This delivery and returns policy is subject to change without notice. Please refer to this page for the most current information.
Shipping Policy
At Arumi Companions, we are committed to delivering your order safely, efficiently, and with care. Please review our shipping policy below for details on processing times, shipping methods, and delivery expectations.
Order Processing
-
Orders are typically processed within 1–3 business days (excluding weekends and holidays).
-
Once your order has been processed and shipped, you will receive a shipping confirmation email with tracking information.
-
Processing times may be extended during high-demand periods, promotions, or holidays.
Shipping Methods & Delivery Times
We offer reliable shipping services through trusted carriers.
Estimated delivery times:
-
Standard Shipping: 3–7 business days after shipment
-
Expedited Shipping: 2–3 business days after shipment (if available at checkout)
Delivery times are estimates and may vary due to carrier delays, weather conditions, or other factors beyond our control within the UK.
Shipping Rates
-
Shipping costs are calculated at checkout based on order size, weight, and destination.
-
Any applicable shipping promotions or free shipping offers will be clearly displayed at checkout.
Shipping Locations
United Kingdom Only
-
We currently ship within the United Kingdom only.
-
At this time, we do not offer international shipping.
Order Tracking
Once your order ships, tracking details will be provided via email. Please allow up to 24 hours for tracking information to update.
Shipping Address Accuracy
Please ensure all shipping information is accurate at checkout. Arumi Companions is not responsible for delays, lost packages, or additional fees resulting from incorrect or incomplete address details.
Lost or Delayed Packages
If your package is delayed or appears lost in transit, please contact us at [insert customer support email] and we will assist you in working with the carrier.
Damaged Shipments
If your order arrives damaged, please notify us within 48 hours of delivery. Include photos of the damaged packaging and product so we can promptly assist with a resolution.
Questions
If you have any questions regarding shipping or delivery, please contact our customer service at
Satisfaction Guarantee (PEMF Devices)
At Arumi Companions, we are confident in the quality and craftsmanship of our PEMF wellness devices.
If, within 30 days of delivery, you feel that a PEMF device is not the right fit for your needs, you may contact us to request a return in accordance with the terms below and our Delivery & Returns Policy.
Conditions for PEMF device returns:
-
Applies to first-time PEMF device purchases only
-
Return request must be made within 30 days of delivery
-
Device must be returned complete, undamaged, and in original packaging
-
Devices showing signs of misuse, damage, or excessive wear may not be eligible
-
Return shipping costs are the responsibility of the customer unless the item is faulty
This satisfaction guarantee is offered in addition to your statutory rights under UK consumer law and reflects our commitment to transparency and elevated customer care.
Accessories & Non-Electronic Products
Accessories and non-electronic items (including covers, wraps, straps, and similar products) are subject to standard UK return rights.
-
Customers may request a return within 14 days of delivery under the Consumer Contracts Regulations 2013
-
Items must be unused, in original condition, and in original packaging
-
For hygiene and safety reasons, certain accessories may be non-returnable unless faulty
-
Return shipping costs are the responsibility of the customer unless the item is faulty or incorrect
Faulty or Incorrect Items (UK Statutory Rights)
Nothing in this policy affects your statutory rights.
If an item is faulty, damaged, or not as described, you are entitled to a repair, replacement, or refund in accordance with the Consumer Rights Act 2015. Please notify us as soon as reasonably possible so we can resolve the issue promptly.
Important Notes
-
Satisfaction guarantees relate to product suitability, not therapeutic outcomes
-
PEMF products are wellness support devices and are not medical treatments
-
This policy operates alongside—and not in place of—your statutory consumer rights
Contact
For all delivery, returns, or guarantee enquiries, please contact:
contact@arumicompanions.co.uk